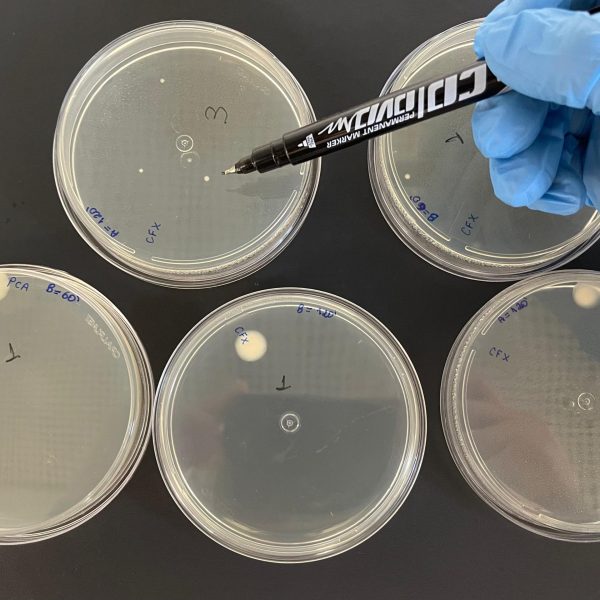

O SIMOA conta com uma infraestrutura composta por quatro unidades laboratoriais e uma unidade experimental semi-piloto.
Laboratório de Sistemas Inteligentes de Monitoramento Ambiental (LabSIMOA)
O LabSIMOA é um laboratório de pesquisa dedicado ao desenvolvimento de soluções avançadas para a avaliação e monitoramento de parâmetros ambientais. Com uma infraestrutura completa, o LabSIMOA é apto a conduzir estudos inovadores na área de monitoramento ambiental, combinando metodologias in situ e técnicas de sensoriamento remoto.
As principais linhas de pesquisa desenvolvidas no laboratório incluem:
- Avaliação in situ da qualidade da água, com a utilização de sondas multiparâmetros capazes de monitorar diversos indicadores:
- Levantamentos aerofotogramétricos multiespectrais e hiperespectrais, realizados por meio de drones equipados com sensores de última geração:
- Processamento e análise avançada de imagens aéreas e de satélite, visando a geração de ortomosaicos e produtos derivados para o monitoramento ambiental:
Com uma equipe multidisciplinar e infraestrutura de ponta, o labSIMOA contribui ativamente para o avanço do conhecimento e o desenvolvimento de soluções tecnológicas aplicadas à conservação e gestão dos recursos naturais.
Localização: Departamento de Engenharia Sanitária e Ambiental – Avenida Antônio Carlos, 6627, Bloco 1, Pampulha, Belo Horizonte – MG, 31270-901. Sala 4626
Laboratório de Análises Instrumentais
O Laboratório de Análises Instrumentais permite o desenvolvimento de metodologias avançadas para a detecção e quantificação de analitos de interesse em estudos ambientais. Equipado com instrumentação de última geração, o laboratório contribui ativamente para o avanço do conhecimento e a aplicação de técnicas analíticas inovadoras.
Com uma equipe multidisciplinar e infraestrutura analítica de ponta, as principais linhas de pesquisa do laboratório incluem:
- Monitoramento ambiental de microcontaminantes, contaminantes emergentes e subprodutos de degradação em diversos compartimentos, como água, solo e ar, permitindo pesquisas acerca da dinâmica e o destino desses compostos no ambiente;
- Desenvolvimento e aprimoramento de métodos analíticos utilizando técnicas instrumentais modernas, como cromatografia e espectrometria de massas, que permitem a detecção e quantificação precisa de uma ampla gama de analitos;
- Aplicação de técnicas avançadas de preparo de amostra, como extração em fase sólida (SPE), microextração em fase sólida (SPME) e técnicas de clean-up, visando otimizar a eficiência e a seletividade das análises;
- Estudos sobre a ocorrência, distribuição, transformação e impactos de microcontaminantes, contaminantes emergentes e subprodutos de degradação em diferentes ecossistemas, contribuindo para a avaliação de riscos e o desenvolvimento de estratégias de mitigação.
Localização: Departamento de Engenharia Sanitária e Ambiental – Avenida Antônio Carlos, 6627, Bloco 1, Pampulha, Belo Horizonte – MG, 31270-901. Sala 4551
Laboratório de Ecotoxicologia (ECOA)
O Laboratório ECOA conta com uma equipe multidisciplinar e infraestrutura especializada, desempenhando um papel fundamental na geração de conhecimento e no desenvolvimento de soluções para a avaliação e mitigação dos impactos ambientais. O laboratório é especializado no estudo dos efeitos tóxicos de amostras ambientais, com ênfase na avaliação da ecotoxicidade de águas, efluentes e sedimentos. Equipado com infraestrutura especializada, o ECOA desenvolve pesquisas que visam compreender o impacto de contaminantes sobre organismos-teste representativos de diferentes níveis tróficos.
As principais linhas de pesquisa do laboratório incluem:
- Caracterização ecotoxicológica de amostras, utilizando uma variedade de organismos-teste, como bactérias (Aliivibrio fischeri), microalgas (Raphidocelis subcapitata), invertebrados aquáticos (Hyalella azteca) e leveduras (Saccharomyces cerevisiae), permitindo avaliar os efeitos tóxicos agudos e crônicos das amostras;
- Estudos sobre a toxicidade de efluentes industriais, com ênfase na avaliação da eficiência de Processos Oxidativos Avançados (POA), como Foto-Fenton, Fenton, Peroxidação e Ozonização, no tratamento e mitigação dos efeitos ecotoxicológicos;
- Desenvolvimento e aprimoramento de metodologias analíticas, como bioensaios in vitro (Yeast Estrogen Screen – YES) e técnicas de microscopia e espectrofotometria, para a detecção e quantificação de efeitos tóxicos em organismos;
- Avaliação dos efeitos de microcontaminantes, contaminantes emergentes e subprodutos de degradação sobre a biota aquática e terrestre, contribuindo para a compreensão dos impactos ecológicos desses compostos.
Localização: Departamento de Engenharia Sanitária e Ambiental – Avenida Antônio Carlos, 6627, Bloco 1, Pampulha, Belo Horizonte – MG, 31270-901. Sala 4548
Laboratório de Processos Oxidativos Avançados (LabPOA)
O LabPOA se dedica ao desenvolvimento de soluções inovadoras para o monitoramento, caracterização e tratamento de águas e efluentes. Com uma infraestrutura completa, o LabPOA conduz pesquisas e desenvolvimento de soluções ambientais nas áreas de tratamento de águas superficiais, efluentes sanitários e industriais. As estratégias adotadas no tratamento de amostras ambientais englobam sistemas híbridos combinando-se soluções baseadas na natureza (SbN) e Processos Oxidativos Avançados (POAs).
As SbN englobam processos físico, químicos e biológicos (aeróbios ou anaeróbios) que já ocorrem no ambiente natural, mas são maximizadas com técnicas de engenharia para aumentar sua eficiência, com destaque aos sistemas de Wetlands Construídos. Nessa etapa biológica, objetiva-se, principalmente, a remoção de matéria orgânica biodegradável, nutrientes, sólidos suspensos entre outros poluentes convencionais de água e efluentes.
Por outro lado, os POAs (e.g., processos baseados na reação de Fenton, foto-peroxidação, processos fotoquímicos solares, ozonização entre outros) se baseiam na capacidade de geração de radicais oxidativos in situ, ou seja, no próprio sistema de tratamento, visando a remoção de poluentes recalcitrantes, tais como corantes presentes em efluentes de indústria têxtil, matéria orgânica remanescente dos processos biológicos e micropoluentes (fármacos, pesticidas, desreguladores endógenos, entre outros). Além disso, os POAs atuam na desinfecção e remoção de bactérias e genes de resistência antimicrobiana.
Processos oxidativos avançados aplicados no tratamento de água e efluentes
Em relação à caracterização de amostras de águas e efluentes, a infraestrutura possibilita a determinação dos parâmetros físico-químicos e microbiológicos convencionais, como: pH, temperatura, oxigênio dissolvido, turbidez, série de sólidos, nutrientes (fósforo e nitrogênio), condutividade elétrica, demanda química de oxigênio, demanda bioquímica de oxigênio entre outros, além de coliformes totais e Escherichia coli.
Caracterização físico-química e microbiológica de amostras ambientais
Além da capacidade analítica voltada para parâmetros físico-químicos, o LabPOA também é equipado para a realização de análises biológicas avançadas, incluindo a detecção e quantificação de cianotoxinas e de diversos microrganismos. O laboratório possui expertise e infraestrutura para caracterização da biodiversidade funcional microbiológica da água por meio de técnicas moleculares de última geração, como análise de DNA ambiental (eDNA) e de RNA mensageiro (mRNA). Essas abordagens permitem investigar não apenas a composição taxonômica, mas também o perfil funcional e a expressão gênica das comunidades microbianas, fornecendo informações essenciais para o monitoramento ambiental e para a avaliação de riscos à saúde pública.
Com uma equipe multidisciplinar e infraestrutura de ponta, o LabPOA contribui ativamente para o avanço do conhecimento e o desenvolvimento de tecnologias aplicadas ao tratamento de efluentes e à conservação dos recursos naturais.
A infraestrutura do LabPOA conta com: agitadores magnéticos; balança analítica; banho de aquecimento; banho termostático; banho ultrassônico; bomba de vácuo; bombas dosadoras e peristálticas; capela de segurança química; centrífuga; destilador, termodigestores para análise de DQO; espectofotômetro Hach DR6000; estufa; equipamentos de Jar Test; equipamento de flotação por ar dissolvido; gerador de ar e ozônio; manifold para extração em fase sólida; medidor de oxigênio dissolvido de bancada; multiparâmetro YSI; medidores de pH de bancada e portátil; purificador de água ultrapura Mili-Q; rotaevaporador; turbídimetro, entre outros equipamentos.
Localização: Departamento de Engenharia Sanitária e Ambiental – Avenida Antônio Carlos, 6627, Bloco 1, Pampulha, Belo Horizonte – MG, 31270-901. Sala 4542
Unidade Experimental de Tratamentos Avançados
O SIMOA, além de sua robusta estrutura laboratorial, dispõe de unidades experimentais em escala semi-piloto. Esta unidade desempenha um papel crucial na transição entre a pesquisa laboratorial e as aplicações práticas em larga escala, permitindo o escalonamento dos tratamentos desenvolvidos inicialmente em ambiente controlado. Nesta unidade, é possível simular condições ambientais que se aproximam da realidade, proporcionando uma plataforma ideal para a verificação e otimização das melhores condições de tratamento. Essa abordagem permite uma avaliação mais precisa da eficácia e viabilidade dos processos antes de sua implementação em escala real.
A unidade conta com fotorreatores solares do tipo CPC (Compound Parabolic Collector) e RPR (Raceway Pond Reactor), projetados para aproveitar a radiação solar de forma eficiente. Esses reatores inovadores são fundamentais para impulsionar processos fotoquímicos avançados no tratamento de água e efluentes, representando uma abordagem sustentável e economicamente viável. A combinação de diferentes tipos de reatores permite uma ampla gama de experimentos, abrangendo desde tratamentos intensivos de pequeno volume até processos de maior escala. Esta versatilidade posiciona a Unidade Experimental como um elo essencial entre a pesquisa acadêmica e as aplicações práticas, acelerando o desenvolvimento de soluções inovadoras para os desafios ambientais contemporâneos.
- Raceway Pond Reactor:
|
Esse reator, semelhante a um canal raso em forma de circuito fechado, suporta um volume máximo de 12 L, mantendo uma profundidade da lâmina d’água equivalente a 5 cm. O sistema de agitação acoplado possibilita a homogeneização da amostra e dos reagentes dosados durante o tratamento. Um radiômetro, acoplado ao reator, mede a radiação incidente nos comprimentos de onda de 200-400 nm. O sitema também conta com um datalogger, o que permite o monitoramento dos dados de radiação a cada minuto de reação. |
- Compound Parabolic Collector:
|
Diferentemente dos reatores RPR, o CPC utiliza coletores parabólicos para concentrar a luz solar, aumentando a eficiência da iluminação. O reator utilizado pelo SIMOA possui uma capacidade total de 45 L, operando com um volume de 15 L para cada dois tubos, possibilitando a realização de experimentos simultâneos. O reator possui uma inclinação de 20°, correspondente à latitude da cidade de Belo Horizonte. Nessa mesma inclinação, encontra-se o radiômetro acoplado ao reator, medindo a radiação incidente nos comprimentos de onda de 200-400 nm. O sitema também conta com um datalogger, o que permite o monitoramento dos dados de radiação a cada minuto de reação. Como esse sistema pode aquecer rapidamente devido à concentração de luz, é realizado o monitoramento constante da temperatura nos três reservatórios do reator. |
Além disso, a unidade conta com biorreatores que simulam os sistemas de wetlands construído. Considerados como tecnologias de soluções baseadas na natureza (SbN), o SIMOA conta com reatores de leito fixo plantado (RFP), um sistema infinitesimal que representa em nanoescala o que acontece nas wetlands construídos de fluxo horizontal. A partir dos estudos realizados é possivel definir melhores condições para tratamento de águas superficiais e efluentes industriais, sendo um dos principais objetivos a definição do melhor meio suporte, de forma a reduzir a carga de nutrientes e matéria orgânica que podem impactar negativamente a qualidade da água.
- Sistema baseado na natureza instalado para tratamento de efluentes industriais